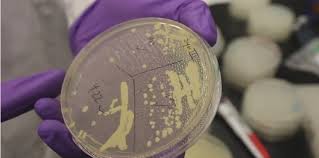

Le plus gigantesque dinosaure a été découvert au sud de l’Argentine
Incroyable !! Le sud de l’Argentine cachait un trésor que les paléontologues ont découvert avec beaucoup d’émotion. Il s’agit du plus gros dinosaure jamais connu ! Baptisé dreadnoughtus schrani, son fossile a été parfaitement conservé. Il semble que la découverte faite au sud de l’Argentine , en Patagonie, soit la plus impressionnante et la plus complète découverte…